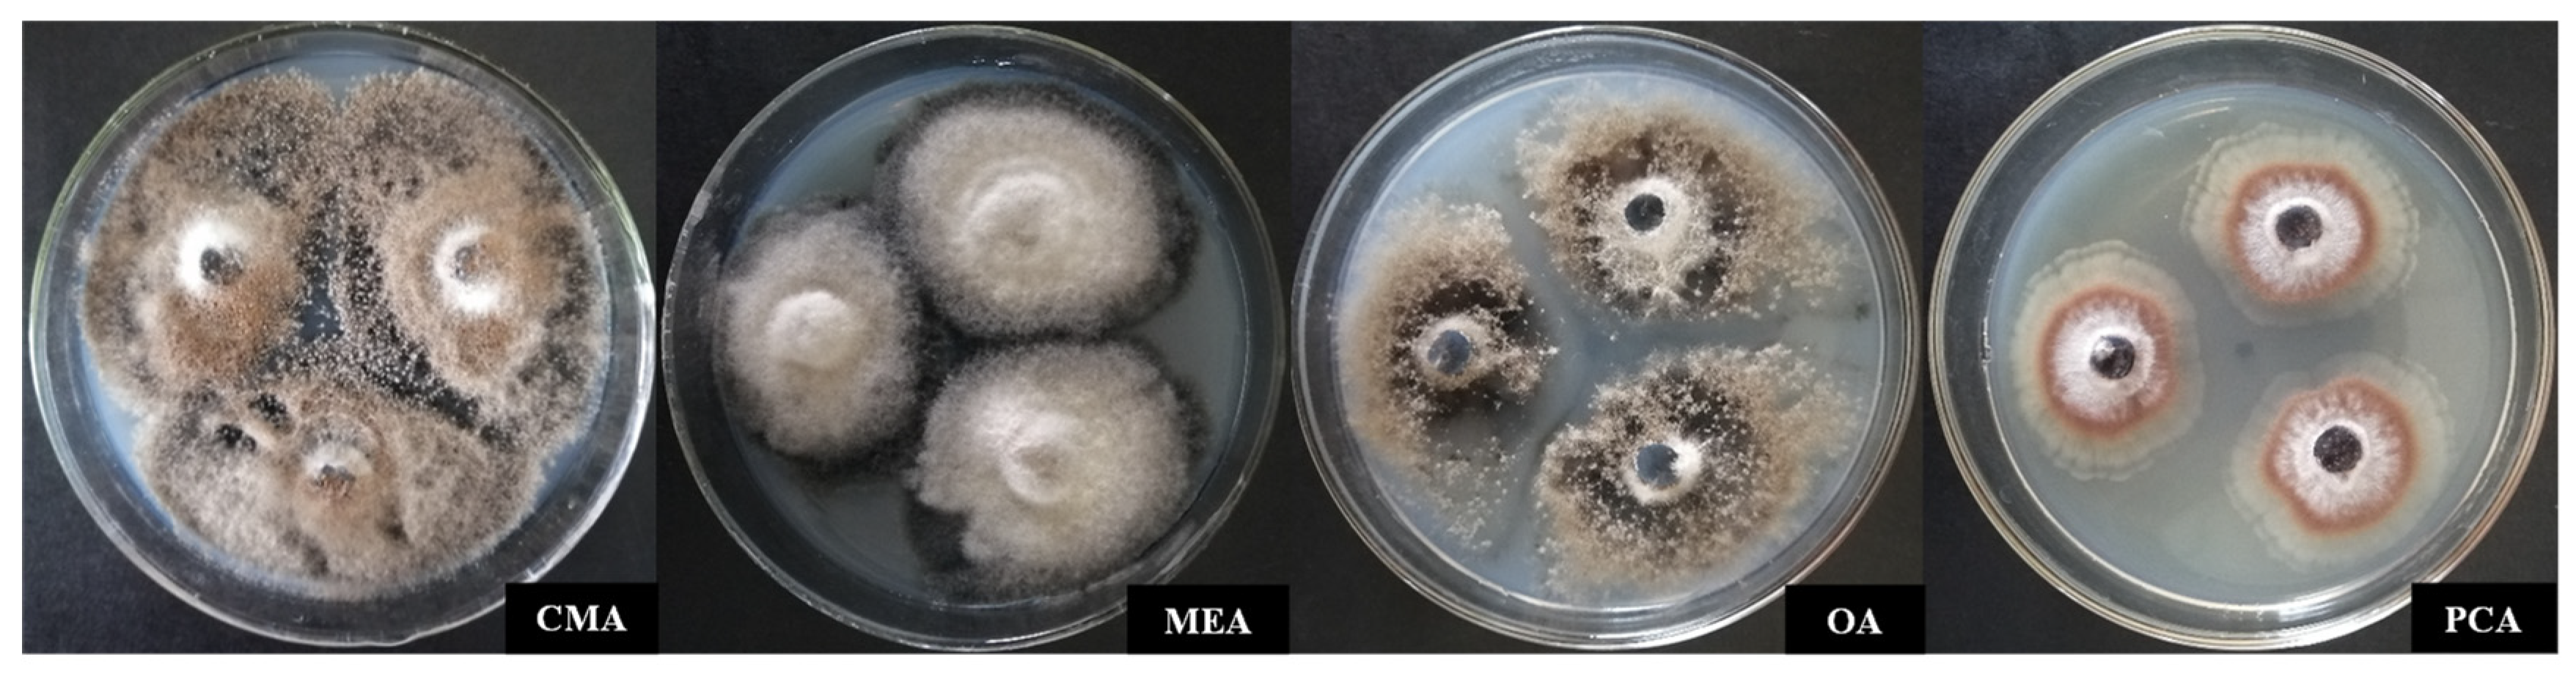
Agronomy 12 02906 g002 Agronomy 12 02906 g002
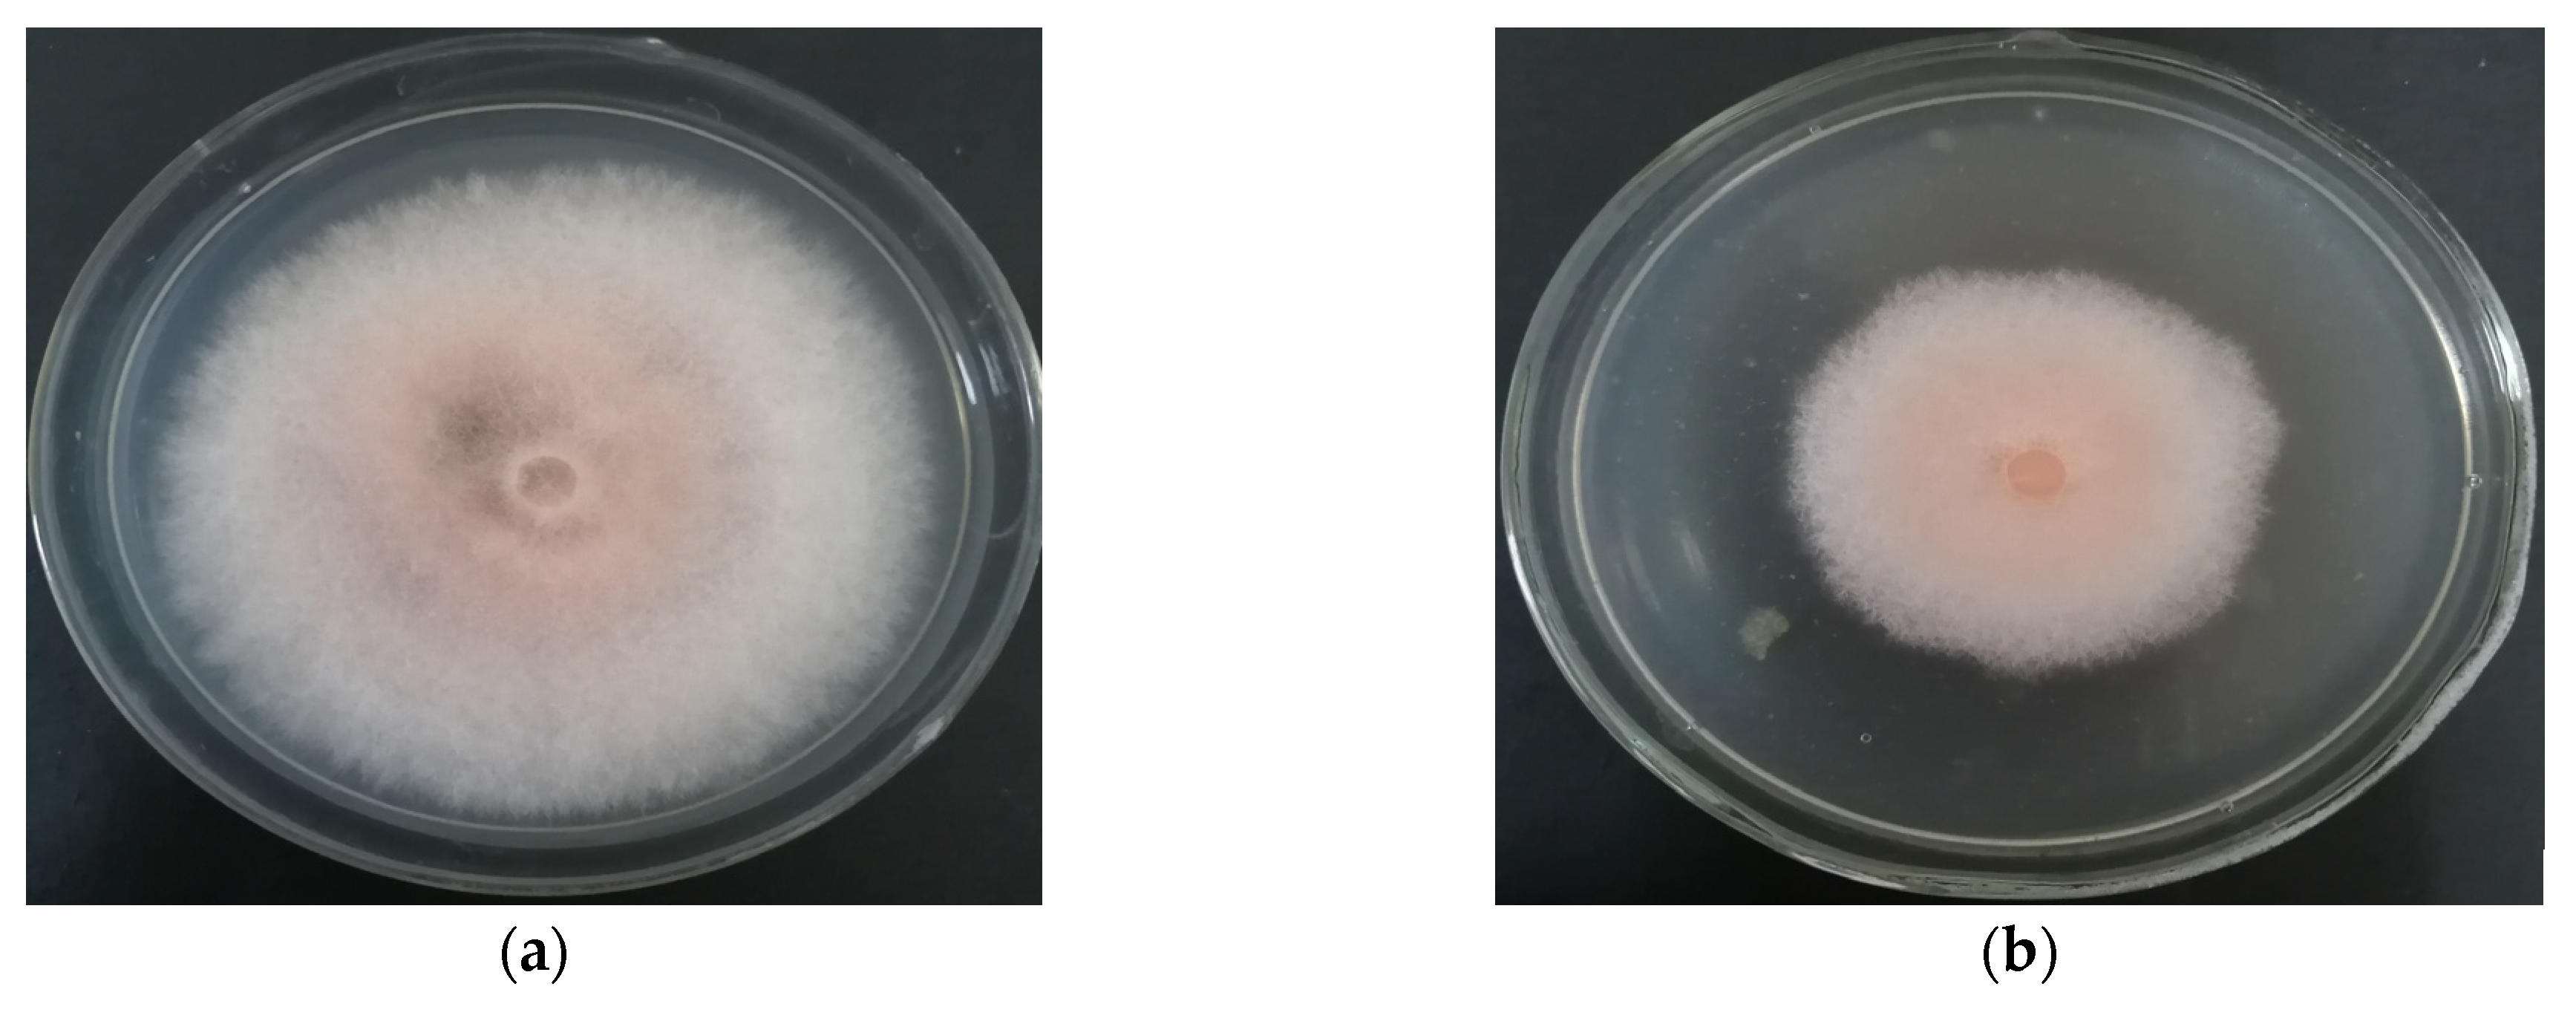
Agronomy 12 02906 g005a Agronomy 12 02906 g005a

Effect of Rhizospheric Fungus on Biological Control of Root Rot (Fusarium equiseti) Disease of Saposhnikovia divaricata
Abstract
1. Introduction
2. Materials and Methods
2.1. Microorganisms
2.2. In Vitro Antifungal Activity
2.3. Identification of MR-57 Isolate
2.4. Antagonistic Activity of MR-57 on Mycelial Growth of F. equiseti
2.5. Antagonistic Activity of MR-57 on Conidial Germination of F. equiseti
2.6. Soil Colonization Assays
2.7. Biocontrol of MR-57 Isolate
2.8. Plant Growth Promotion of MR-57 Isolate
2.9. Statistical Analysis
3. Results
3.1. Antagonistic Activities of Fungal Isolates against F. equiseti
3.2. Antifungal Spectrum of MR-57 Isolate
3.3. Identification of Antagonistic Strain MR-57
3.3.1. Identification of Culture Characteristics
3.3.2. Identification of Microscopic Features
3.3.3. Sequence and Phylogenetic Analysis
3.4. MR-57 Culture Filtrate against Mycelia of F. equiseti
3.5. MR-57 Culture Filtrate Assay on Spore Germination of F. equiseti
3.6. Soil Colonization Ability of MR-57 Isolate
3.7. Biocontrol Efficiency of MR-57 against Root Rot of S. divaricata
3.8. Effects of MR-57 on Plant Growth Characteristics of S. divaricata
4. Discussion
5. Conclusions
Supplementary Materials
Author Contributions
Funding
Conflicts of Interest
References
- Li, X.; Xu, S.; Zhang, J.; Li, M. Assembly and annotation of whole-genome sequence of Fusarium equiseti. Genomics 2021, 113, 2870–2876. [Google Scholar] [CrossRef] [PubMed]
- Marin, P.; Jurado, M.; Gonzalez-Jaen, M.T. Growth rate and TRI5 gene expression profiles of Fusarium equiseti strains isolated from Spanish cereals cultivated on wheat and barley media at different environmental conditions. Int. J. Food Microbiol. 2015, 195, 40–47. [Google Scholar] [CrossRef] [PubMed][Green Version]
- Xue, W. Pathogen Identification and Pesticides Screening Indoor for Diseases of Saposhnikovia divaricata (Turcz.) Schischk; Jilin Agricultural University: Changchun, China, 2008. [Google Scholar]
- National Pharmacopoeia Committee. Pharmacopoeia of the People’s Republic of China (Vol. I); China Medical Science Press: Beijing, China, 2020; p. 156. [Google Scholar]
- Chen, S.; Zhuang, T.; Fang, W.; Sheng, G.; Jin, Y.; Liu, L.; Sun, B.; Hu, Z.; Wang, S. Delectis Florae Reipublicae Popularis Sinicae Agendae Academiae Sinicae Edita. In Flora Reipublicae Popularis Sinicae; Tomus 55(3); Science Press: Beijing, China, 1992; p. 222. [Google Scholar]
- Gao, F.; Chen, Y.; Dai, Z.; Guo, H.; Wu, Q.; Chen, H.; Qi, J.; Li, T.; Chen, K.; Wang, Y.; et al. Investigation of the mechanism of Fangfeng Tongsheng Pills in the treatment COVID-19 by network pharmacology and molecular docking. Northwest Pharm. J. 2022, 37, 36–43. [Google Scholar]
- Zhou, J.; Sun, Y.Y.; Sun, M.Y.; Mao, W.A.; Wang, L.; Zhang, J.; Zhang, H. Prim-O-glucosylcimifugin attenuates lipopolysaccharide- induced inflammatory response in RAW 264.7 macrophages. Pharmacogn. Mag. 2017, 13, 378–384. [Google Scholar]
- Yang, J.M.; Jiang, H.; Dai, H.L.; Wang, Z.W.; Jia, G.Z.; Meng, X.C. Feeble antipyretic, analgesic, and anti-inflammatory activities were found with tegular dose 4′-O-beta-D-glucosyl-5-O-methylvisamminol, one of the conventional marker compounds for quality evaluation of Radix Saposhnikoviae. Pharmacogn. Mag. 2017, 13, 168–174. [Google Scholar]
- Kreiner, J.; Pang, E.; Lenon, G.B.; Yang, A.W.H. Saposhnikoviae divaricata: A phytochemical, pharmacological, and pharmacokinetic review. Chin. J. Nat. Med. 2017, 15, 255–264. [Google Scholar] [CrossRef]
- Ma, J.; Tian, Y.; Wang, Z.; Liu, G.; Wang, Z.; Zhang, M. Isolation and identification of endophytic antagonistic bacteria from Saposhnikovia Divaricata. J. Jilin Agric. Univ. 2022, 33, 323–328. [Google Scholar]
- Guo, X.; Tian, X.; Hao, J.; Wang, Y.; Yang, L.; Han, M.; Han, Z. Relationships between Saposhnikovia divaricata chromone content and soil factors in different regions. J. South China Agric. Univ. 2020, 41, 31–37. [Google Scholar]
- Zeng, L. Diseases and Insect Pests of Medicinal Plants; Guizhou Science and Technology Press: Guiyang, China, 2017; p. 222. [Google Scholar]
- Tleuova, A.B.; Wielogorska, E.; Talluri, V.; Stepanek, F.; Elliott, C.T.; Grigoriev, D.O. Recent advances and remaining barriers to producing novel formulations of fungicides for safe and sustainable agriculture. J. Control. Release 2020, 326, 468–481. [Google Scholar] [CrossRef]
- Sare, A.R.; Jijakli, M.H.; Massart, S. Microbial ecology to support integrative efficacy improvement of biocontrol agents for postharvest diseases management. Postharvest Biol. Technol. 2021, 179, 111572. [Google Scholar] [CrossRef]
- Bollmann-Giolai, A.; Malone, J.G.; Arora, S. Diversity, detection and exploitation: Linking soil fungi and plant disease. Curr. Opin. Microbiol. 2022, 70, 102199. [Google Scholar] [CrossRef] [PubMed]
- Lecomte, C.; Alabouvette, C.; Edel-Hermann, V.; Robert, F.; Steinberg, C. Biological control of ornamental plant diseases caused by Fusarium oxysporum: A review. Biol. Control 2016, 101, 17–30. [Google Scholar] [CrossRef]
- Xi, X.; Fan, J.; Yang, X.; Liang, Y.; Zhao, X.; Wu, Y. Evaluation of the anti-oomycete bioactivity of rhizosphere soil-borne isolates and the biocontrol of soybean root rot caused by Phytophthora sojae. Biol. Control 2022, 166, 104818. [Google Scholar] [CrossRef]
- Kumawat, K.C.; Razdan, N.; Saharan, K. Rhizospheric microbiome: Bio-based emerging strategies for sustainable agriculture development and future perspectives. Microbiol. Res. 2022, 254, 126901. [Google Scholar] [CrossRef]
- Philippot, L.; Raaijmakers, J.M.; Lemanceau, P.; Van der Putten, W.H. Going back to the roots: The microbial ecology of the rhizosphere. Nat. Rev. Microbiol. 2013, 11, 789–799. [Google Scholar] [CrossRef]
- Zhang, H.; Kong, N.; Liu, B.; Yang, Y.; Li, C.; Qi, J.; Ma, Y.; Jia, S.; Liu, Z. Biocontrol potential of Trichoderma harzianum CGMCC20739 (Tha739) against post-harvest bitter rot of apples. Microbiol. Res. 2022, 265, 127182. [Google Scholar] [CrossRef]
- Perea-Molina, P.A.; Pedraza-Herrera, L.A.; Beauregard, P.B.; Uribe-Vélez, D. A biocontrol Bacillus velezensis strain decreases pathogen Burkholderia glumae population and occupies a similar niche in rice plants. Biol. Control 2022, 176, 105067. [Google Scholar] [CrossRef]
- Sahebani, N.; Gholamrezaee, N. The biocontrol potential of Pseudomonas fluorescens CHA0 against root knot nema-tode (Meloidogyne javanica) is dependent on the plant species. Biol. Control 2021, 152, 104445. [Google Scholar] [CrossRef]
- Samaras, A.; Karaoglanidis, G.S.; Tzelepis, G. Insights into the multitrophic interactions between the biocontrol agent Bacillus subtilis MBI 600, the pathogen Botrytis cinerea and their plant host. Microbiol. Res. 2021, 248, 126752. [Google Scholar] [CrossRef]
- Asad, S.A. Mechanisms of action and biocontrol potential of Trichoderma against fungal plant diseases-A review. Ecol. Complex. 2022, 49, 100978. [Google Scholar] [CrossRef]
- Geng, L.; Fu, Y.; Peng, X.; Yang, Z.; Zhang, M.; Song, Z.; Guo, N.; Chen, S.; Chen, J.; Bai, B.; et al. Biocontrol potential of Trichoderma harzianum against Botrytis cinerea in tomato plants. Biol. Control 2022, 174, 105019. [Google Scholar] [CrossRef]
- Mirsam, H.; Kalqutny, S.H.; Suriani; Aqil, M.; Azrai, M.; Pakki, S.; Muis, A.; Djaenuddin, N.; Rauf, A.W.; Muslimin. Indigenous fungi from corn as a potential plant growth promoter and its role in Fusarium verticillioides suppression on corn. Heliyon 2021, 9, e7926. [Google Scholar]
- Malloch, D. Moulds Their Isolation, Cultivation and Identification; University of Toronto Press: Toronto, ON, Canada, 1981; pp. 1–97. [Google Scholar]
- Bunbury-Blanchette, A.L.; Walker, A.K. Trichoderma species show biocontrol potential in dual culture and greenhouse bioassays against Fusarium basal rot of onion. Biol. Control 2019, 130, 127–135. [Google Scholar] [CrossRef]
- Costa, D.; Tavares, R.M.; Baptista, P.; Lino-Neto, T. Cork oak endophytic fungi as potential biocontrol agents against Biscogniauxia mediterranea and Diplodia corticola. J. Fungi 2020, 6, 287. [Google Scholar] [CrossRef] [PubMed]
- Zhang, Y.; Liu, F.; Wu, W.; Cai, L. A phylogenetic assessment and taxonomic revision of the thermotolerant hyphomycete genera Acrophialophora and Taifanglania. Mycologia 2015, 107, 768–779. [Google Scholar] [CrossRef]
- Liu, Q.; Chen, S. Two novel species of Calonectria isolated from soil in a natural forest in China. MycoKeys 2017, 26, 25–60. [Google Scholar] [CrossRef]
- Millan, A.F.S.; Larraya, L.; Farran, I.; Ancin, M.; Veramendi, J. Successful biocontrol of major postharvest and soil-borne plant pathogenic fungi by antagonistic yeasts. Biol. Control 2021, 160, 104683. [Google Scholar] [CrossRef]
- Zhang, Q.; Zhao, L.; Li, Z.; Li, C.; Li, B.; Gu, X.; Zhang, X.; Zhang, H. Screening and identification of an antagonistic yeast controlling postharvest blue mold decay of pears and the possible mechanisms involved. Biol. Control 2019, 133, 26–33. [Google Scholar] [CrossRef]
- Darma, S.; Ambara, A.; Aman, A.T.; Annisa, L.; Nurrokhman; Nuryastuti, T.; Wibawa, T. High frequency of azole resistant Candida spp. colonization among presumptive multidrug resistant tuberculosis (MDR-TB) patients. PLoS ONE 2020, 15, e242542. [Google Scholar] [CrossRef] [PubMed]
- Chen, S.; Jin, W.; Liu, A.; Zhang, S.; Liu, D.; Wang, F.; Lin, X.; He, C. Arbuscular mycorrhizal fungi (AMF) increase growth and secondary metabolism in cucumber subjected to low temperature stress. Sci. Hortic. 2013, 160, 222–229. [Google Scholar] [CrossRef]
- Gholami, M.; Amini, J.; Abdollahzadeh, J.; Ashengroph, M. Basidiomycetes fungi as biocontrol agents against take-all disease of wheat. Biol. Control 2018, 130, 34–43. [Google Scholar] [CrossRef]
- Huang, L.; Niu, Y.; Su, L.; Deng, H.; Lyu, H. The potential of endophytic fungi isolated from cucurbit plants for biocontrol of soilborne fungal diseases of cucumber. Microbiol. Res. 2020, 231, 126369. [Google Scholar] [CrossRef] [PubMed]
- Wang, X.; Bai, F.; Bensch, K.; Meijer, M.; Sun, B.; Han, Y.F.; Crous, P.W.; Samson, R.A.; Yang, F.; Houbraken, J. Phylogenetic re-evaluation of Thielavia with the introduction of a new family Podosporaceae. Stud. Mycol. 2019, 93, 155–252. [Google Scholar] [CrossRef] [PubMed]
- Zhang, T. Flora Fungorum Sinicorum. Vol. 51 Dematiaceous Hyphomycetes from Soil; Science Press: Beijing, China, 2019; pp. 240–243. [Google Scholar]
- Lodha, B.C. Studies on coprophilous fungi. J. Indian Bot. Soc. 1964, 43, 121–140. [Google Scholar]
- Abdel-Hafez, S.I.; Abo-Elyousr, K.A.; Abdel-Rahim, I.R. Leaf surface and endophytic fungi associated with onion leaves and their antagonistic activity against Alternaria porri. Ceska Mykol. 2015, 67, 1–22. [Google Scholar] [CrossRef]
- Demirci, E.; Dane, E.; Eken, C. In vitro antagonistic activity of fungi isolated from sclerotia on potato tubers against Rhizoctonia solani. Turk. J. Biol. 2011, 35, 457–462. [Google Scholar] [CrossRef]
- Daroodi, Z.; Taheri, P.; Tarighi, S. Endophytic fungus Acrophialophora jodhpurensis induced resistance against tomato early blight via interplay of reactive oxygen species, iron and antioxidants. Mol. Plant Pathol. 2021, 115, 101681. [Google Scholar] [CrossRef]
- Ramzan, N.R.; Shahzad, S. Inhibition of in vitro growth of soil-borne pathogens by compost-inhabiting indigenous bacteria and fungi. Pak. J. Bot. 2014, 46, 1093–1099. [Google Scholar]
- Ameen, F.; Al-Homaidan, A.A. Improving the efficiency of vermicomposting of polluted organic food wastes by adding biochar and mangrove fungi. Chemosphere 2022, 286, 131945. [Google Scholar] [CrossRef]
- Kepler, R.M.; Maul, J.E.; Rehner, S.A. Managing the plant microbiome for biocontrol fungi: Examples from Hypocreales. Curr. Opin. Microbiol. 2017, 37, 48–53. [Google Scholar] [CrossRef]
- Barros, R.R.O.; Oliveira, R.A.; Gottschalk, L.M.F.; Bon, E.P.S. Production of cellulolytic enzymes by fungi Acrophialophora nainiana and Ceratocystis paradoxa using different carbon sources. Appl. Biochem. Biotechnol. 2010, 161, 448–454. [Google Scholar] [CrossRef] [PubMed]
- Silveira, M.H.L.; Siqueira, F.G.D.; Rau, M.; Silva, L.D.; Moreira, L.R.D.S.; Ferreira-Filho, E.X.; Andreaus, J. Hydrolysis of sugarcane bagasse with enzyme preparations from Acrophialophora nainiana grown on different carbon sources. Biocatal. Biotransform. 2014, 32, 53–63. [Google Scholar] [CrossRef]
- Celestino, S.M.C.; Freitas, S.M.D.; Javier, M.F.J.; Sousa, M.V.D.; Filho, F.E.X. Purification and characterization of a novel pectinase from Acrophialophora nainiana with emphasis on its physicochemical properties. J. Biotechnol. 2006, 123, 33–42. [Google Scholar] [CrossRef] [PubMed]
- Soni, H.; Rawat, H.K.; Ahirwar, S.; Kango, N. Screening, statistical optimized production, and application of β-mannanase from some newly isolated fungi. Eng. Life Sci. 2017, 17, 392–401. [Google Scholar] [CrossRef]
- Xian, H.; Liu, L.; Li, Y.; Yang, Y.; Yang, S. Molecular tagging of biocontrol fungus Trichoderma asperellum and its colonization in soil. J. Appl. Microbiol. 2020, 128, 255–264. [Google Scholar] [CrossRef]
- Daroodi, Z.; Taheri, P.; Tarighi, S. Direct antagonistic activity and tomato resistance induction of the endophytic fungus Acrophialophora jodhpurensis against Rhizoctonia solani. Biol. Control 2021, 160, 104696. [Google Scholar] [CrossRef]
- Jiang, Z.; Guo, J. Hazard analysis of the impact of biocontrolling microbes on soil micro-ecosystem. J. Microbiol. 2006, 26, 85–88. [Google Scholar]

| Treatment | Spore Germination Rate (%) | Inhibition Rate at 48 h (%) | |||
|---|---|---|---|---|---|
| 6 h | 12 h | 24 h | 48 h | ||
| Sterile distilled water (CK) | 37.00 ± 5.91 a | 43.19 ± 4.45 a | 58.60 ± 6.40 a | 86.03 ± 10.24 a | — |
| MR-57 | 3.84 ± 1.14 b | 8.26 ± 0.56 b | 22.88 ± 5.83 b | 24.93 ± 3.74 b | 71.01 ± 2.40 |
| F value | 92.905 | 181.365 | 51.051 | 94.194 | |
| p value | 0.0006 | 0.0002 | 0.002 | 0.0006 | |
| Treatment | Disease Index | Disease Control (%) |
|---|---|---|
| MR-57 | 22.18 ± 3.72 c | 65.41 ± 5.80 a |
| Mancozeb 70% WP | 23.44 ± 2.11 c | 63.44 ± 3.30 a |
| B. subtilis | 32.07 ± 5.66 b | 49.99 ± 8.82 b |
| T. harzianum | 30.85 ± 4.29 b | 51.89 ± 6.70 b |
| Clear water (CK) | 64.14 ± 2.18 a | — |
| F value | 59.701 | 4.434 |
| p value | 0.0001 | 0.0409 |
| Treatment | Stem Length (cm) | Root Length (cm) | Seedling Fresh Weight (g) | Root Fresh Weight (g) | Seedling Dry Weight (g) | Root Dry Weight (g) |
|---|---|---|---|---|---|---|
| MR-57 | 27.71 ± 3.22 ns | 30.36 ± 2.88 ns | 20.18 ± 3.09 a | 6.64 ± 0.81 a | 4.94 ± 0.77 a | 1.43 ± 0.03 a |
| B. subtilis | 24.49 ± 4.38 ns | 29.14 ± 2.76 ns | 10.44 ± 0.80 b | 4.10 ± 0.71 b | 2.56 ± 0.69 b | 0.85 ± 0.07 b |
| T. harzianum | 24.32 ± 5.53 ns | 28.03 ± 3.83 ns | 11.97 ± 1.22 b | 4.16 ± 0.28 b | 3.19 ± 0.12 b | 0.90 ± 0.25 b |
| Clear water (CK) | 24.31 ± 5.05 ns | 27.96 ± 2.33 ns | 9.50 ± 2.48 b | 2.66 ± 0.15 c | 2.41 ± 1.29 b | 0.56 ± 0.15 c |
| F value | 0.391 | 0.426 | 16.013 | 25.963 | 5.857 | 17.842 |
| p value | 0.7626 | 0.74 | 0.001 | 0.0002 | 0.0204 | 0.0007 |
Publisher’s Note: MDPI stays neutral with regard to jurisdictional claims in published maps and institutional affiliations. |
© 2022 by the authors. Licensee MDPI, Basel, Switzerland. This article is an open access article distributed under the terms and conditions of the Creative Commons Attribution (CC BY) license (https://creativecommons.org/licenses/by/4.0/).
Share and Cite
Han, Z.; Cui, Y.; Wang, Y.; Wang, Y.; Sun, Z.; Han, M.; Yang, L. Effect of Rhizospheric Fungus on Biological Control of Root Rot (Fusarium equiseti) Disease of Saposhnikovia divaricata. Agronomy 2022, 12, 2906. https://doi.org/10.3390/agronomy12112906
Han Z, Cui Y, Wang Y, Wang Y, Sun Z, Han M, Yang L. Effect of Rhizospheric Fungus on Biological Control of Root Rot (Fusarium equiseti) Disease of Saposhnikovia divaricata. Agronomy. 2022; 12(11):2906. https://doi.org/10.3390/agronomy12112906
Chicago/Turabian StyleHan, Zhongming, Yi Cui, Yan Wang, Yunhe Wang, Zhuo Sun, Mei Han, and Limin Yang. 2022. "Effect of Rhizospheric Fungus on Biological Control of Root Rot (Fusarium equiseti) Disease of Saposhnikovia divaricata" Agronomy 12, no. 11: 2906. https://doi.org/10.3390/agronomy12112906
APA StyleHan, Z., Cui, Y., Wang, Y., Wang, Y., Sun, Z., Han, M., & Yang, L. (2022). Effect of Rhizospheric Fungus on Biological Control of Root Rot (Fusarium equiseti) Disease of Saposhnikovia divaricata. Agronomy, 12(11), 2906. https://doi.org/10.3390/agronomy12112906

